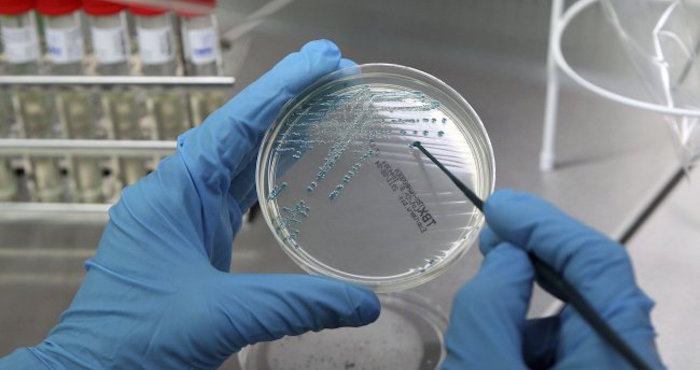
El Día Mundial del Cáncer, que se celebra cada 4 de febrero, llama nuestra atención sobre una enfermedad que continúa azotando la sociedad. Foto: EFE

El informe nos recuerda que un tercio de la población deberá enfrentarse al cáncer, pero también que está en nuestra mano evitar los factores de riesgo y facilitar la detección precoz. Estas consignas básicas son, o al menos deberían ser, moneda común para todos los ciudadanos. Mucho menos conocidos son estos diez datos sobre el cáncer, todos ellos fruto de recientes investigaciones.
Por Javier Yanes
Ciudad de México, 04 febrero (SinEmbargo/The Huffington Post).- El Día Mundial del Cáncer, que se celebra cada 4 de febrero, llama nuestra atención sobre una enfermedad que continúa azotando la sociedad, pero que cada vez es más accesible a las terapias. La Sociedad Española de Oncología Médica aprovecha esta fecha para publicar su estudio Las cifras del cáncer, que resume el panorama actual de la enfermedad en nuestro país.
El informe nos recuerda que un tercio de la población deberá enfrentarse al cáncer, pero también que está en nuestra mano evitar los factores de riesgo y facilitar la detección precoz. Estas consignas básicas son, o al menos deberían ser, moneda común para todos los ciudadanos. Mucho menos conocidos son estos diez datos sobre el cáncer, todos ellos fruto de recientes investigaciones.
1.- LAS PALOMAS PUEDEN RECONOCERLO
Pese a que su presencia en los parques no es del gusto de todos y hay quienes llegan a considerarlas una plaga urbana, las palomas son animales con unas habilidades sorprendentes. Varios estudios han demostrado que pueden distinguir los rostros de las personas y sus expresiones, son capaces de identificar las letras del alfabeto, y diferencian entre un cuadro de Picasso y otro de Monet, o entre la música de Bach y la de Stravinsky.
Sólo les faltaba reconocer el cáncer, y esto es lo que ha logrado un equipo de investigadores de tres Universidades de Estados Unidos. Los científicos han entrenado a un grupo de palomas para distinguir el tejido sano del tumoral en biopsias y radiografías de cánceres de mama. Con este trabajo los investigadores no pretenden reemplazar a los patólogos por aves, sino entender cómo los humanos aprenden esa misma habilidad y ayudar al desarrollo de herramientas de análisis de imágenes médicas.
2. Y LOS PERROS PUEDEN OLERLO
Los perros tienen un sentido del olfato entre 10 mil y 100 mil veces más sensible que el nuestro, pudiendo detectar moléculas a concentraciones muy bajas en el aire. Los humanos hemos aprovechado este fino olfato canino para diversos usos, a los que ahora se suma uno más: oler el cáncer.
Un equipo de investigadores de la Universidad de California en Davis [EU] ha entrenado a dos cachorros, Alfie y Charlie, para detectar el olor del cáncer en muestras de orina o saliva. Los científicos aún no saben cuáles son los compuestos volátiles en las secreciones humanas que los perros son capaces de detectar, pero los animales logran una tasa de éxito del 95 por ciento en la identificación de cánceres en fase temprana.
3. ALGUNOS TUMORES CEREBRALES SE ALIMENTAN DE PENSAMIENTOS
Parece absurdo, pero es literalmente cierto. Investigadores de la Universidad de Stanford [EU] demostraron el pasado año que la actividad de las neuronas estimula el crecimiento de un tipo de cánceres cerebrales fatales llamados gliomas.
Los científicos extrajeron tejido tumoral de pacientes y lo trasplantaron a la corteza cerebral de ratones, cuya actividad podían controlar mediante una técnica que estimula las neuronas con luz. El resultado fue que los tumores crecían al aumentar la actividad neuronal gracias a una proteína que se produce y que fomenta la proliferación de las células cancerosas. Según la directora del estudio, Michelle Monje, "el tumor utiliza la función central del cerebro, el pensamiento, para promover su propio crecimiento". Los investigadores buscan ahora una manera de bloquear este efecto.
4. ALGUNOS PARÁSITOS PUEDEN PADECERLO Y TRANSMITIRLO A LOS HUMANOS
En noviembre de 2015 se describió un caso inédito en la historia de la medicina. Un hombre de Medellín [Colombia] infectado por el VIH presentaba un extraño tipo de cáncer nunca visto, hasta que los científicos descubrieron que sus células tumorales no eran humanas, sino del gusano parásito Hymenolepis nana, parecido a una tenia.
El paciente se había infectado con el parásito y las células de este habían proliferado en su organismo como un tumor, aprovechando que su sistema inmunitario estaba debilitado por el VIH. Es un caso único hasta ahora, pero tal vez no sea tan raro: otro estudio sugiere que algunos parásitos unicelulares, como el tripanosoma de la enfermedad del sueño o el toxoplasma, también podrían adquirir un comportamiento canceroso en las personas infectadas.
5. HAY CÁNCERES CONTAGIOSOS [POR SUERTE, NO EN HUMANOS]
El demonio de Tasmania, uno de los animales más populares de la fauna australiana, corre peligro de extinción a causa de un raro mal sin apenas parangones conocidos en la naturaleza: un cáncer transmisible. La enfermedad del tumor facial del demonio de Tasmania es un agresivo cáncer que se contagia por mordeduras y que causa la muerte en el 100 por ciento de los casos.
Se descubrió en 1995 y puede acabar con la especie si no se obtiene pronto una vacuna. Lo habitual sería que el sistema inmunitario recharaza las células de otro individuo, pero la baja diversidad genética de estos animales hace que su organismo no reconozca el tumor como ajeno, sino como propio. Solo se conocen otros dos casos de cánceres contagiosos, en perros y en hámsters.
6. HAY UN ANIMAL INMUNE AL CÁNCER [Y NO ES EL TIBURÓN]
El ratopín o rata topo desnuda, un pequeño mamífero africano, es el único animal conocido en el que no se han detectado casos de cáncer. Los investigadores han descubierto que no solo sus células poseen un doble mecanismo de seguridad que impide su proliferación incontrolada, sino que además entre ellas se forma una especie de densa jaula de azúcares que impide la dispersión de un posible tumor.
Otro caso es el del elefante, que sufre una tasa muy baja de cánceres a pesar de poseer muchas más células que otros animales. El secreto de su resistencia parece residir en que posee 40 copias de un gen anticancerígeno llamado p53, del que nosotros solo tenemos dos copias. La ballena boreal es otro animal con alta resistencia al cáncer; su genoma contiene varias mutaciones en genes relacionados con esta enfermedad. En cambio, y al contrario de lo que afirma un mito muy extendido, los tiburones sí padecen cáncer.
7. EL SEXO ORAL ES UN FACTOR DE RIESGO
Desde hace años se conoce la implicación del Virus del Papiloma Humano [VPH] en el desarrollo del cáncer. En realidad se trata de un amplio grupo de virus de transmisión sexual que en general no ocasiona síntomas, o que a lo sumo produce verrugas genitales. En algunos casos, y sin que aún se sepa claramente por qué, el virus provoca un cáncer.
El más habitual es el de cuello de útero, pero el VPH también puede causar tumores en otros órganos sexuales, tanto femeninos como masculinos. Y no solo en los sexuales: hoy se reconoce que el origen de muchos cánceres de boca y garganta es también el VPH, transmitido por la práctica del sexo oral. Es más, en EU se considera ya la causa mayoritaria de los cánceres de boca y garganta, superando al tabaco. Dos casos famosos son el actor Michael Douglas y el cantante de Iron Maiden, Bruce Dickinson. Para prevenirlo, los expertos recomiendan el uso del dique dental, una pieza de látex que evita el contacto directo entre boca y genitales.
8. LOS FACTORES DE RIESGO MÁS IMPROBABLES: OXÍGENO Y MATERIA OSCURA
Conocemos los factores de riesgo cancerígeno sobre los cuales nos advierten las autoridades sanitarias, como el tabaco, la exposición al sol, la obesidad o la vida sedentaria. Pero dado que aún es mucho lo que queda por saber sobre cómo y por qué se origina el cáncer, aún hay margen para identificar otros elementos insospechados. Entre ellos, el gas que respiramos: varios estudios han asociado los altos niveles de oxígeno con el desarrollo del cáncer; el último y más completo se publicó en 2015 y relaciona el oxígeno con el cáncer de pulmón.
Según sus autores, podría deberse al efecto nocivo de la oxidación del ADN celular. Pero más atrevida es la teoría según la cual la materia oscura, ese componente del universo que no podemos ver ni hasta ahora detectar, podría provocar cáncer a través de las alteraciones causadas por su interacción con el ADN. Una hipótesis tan estrafalaria como imposible de refutar, dado que los físicos aún no han logrado cazar la materia oscura.
9. LOS ANTIBIÓTICOS PODRÍAN COMBATIRLO
Una noche, durante la cena, el investigador de la Universidad de Manchester [Reino Unido] Michael Lisanti preguntó a su hija Camilla cómo curaría ella el cáncer. No era una pregunta rara en su contexto, ya que la niña, de ocho años, estaba acostumbrada a escuchar las conversaciones científicas que su padre mantenía con su madre, la también investigadora Federica Sotgia.
Camilla respondió que lo curaría con antibióticos; "como cuando me duele la garganta", dijo. Lisanti pensó que no perdía nada por intentarlo y descubrió que varios antibióticos son capaces de matar las células madre de ocho tipos de tumores en cultivo. El motivo es que estos fármacos inhiben la producción de mitocondrias, las factorías de energía de la célula que son críticas para el crecimiento rápido del tumor. Lisanti confía en que sus estudios puedan abrir una nueva vía de tratamiento del cáncer. De momento, Camilla ya se ha ganado su puesto entre los autores del estudio.
10. UNA VACUNA CONTRA LA MALARIA PODRÍA CURARLO
La ayuda a veces llega de donde menos se la espera, y por mera casualidad. Un grupo de científicos de las Universidades de Copenhague [Dinamarca] y Columbia Británica [Canadá] investigaba una posible vacuna terapéutica contra la malaria para mujeres embarazadas. El parásito de esta enfermedad posee una proteína que se adhiere a un tipo de azúcar presente exclusivamente en la placenta. Pero los científicos han descubierto que este azúcar aparece también en otro tipo de células, las cancerosas.
Los investigadores recrearon la proteína de la malaria añadiéndole una toxina y probaron esta combinación en cultivos tumorales y en ratones con cáncer. Y funciona: la proteína de la malaria se une al azúcar y la célula cancerosa se la traga junto con la toxina, que le provoca la muerte. Los autores del estudio planean ensayar su compuesto en humanos dentro de cuatro años.




